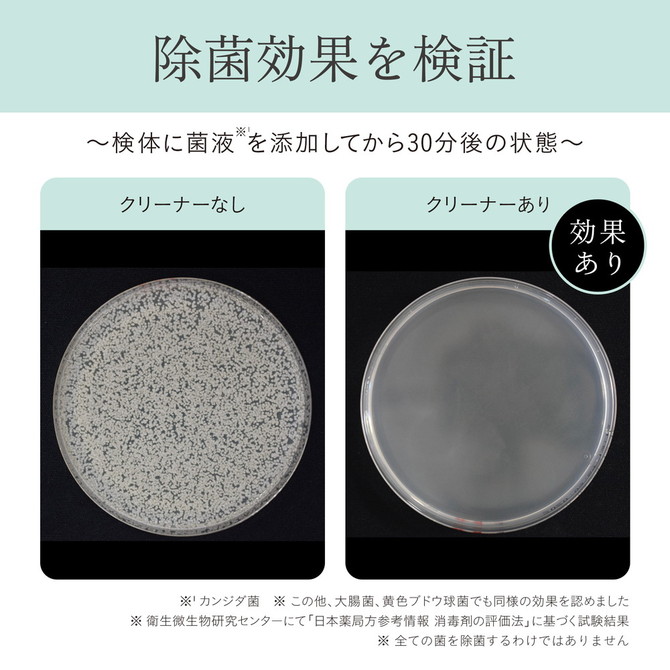

【iroha】ITEM CLEANER (イロハ アイテムクリーナー)
¥1,100
税込
商品コード: 4570030973279
セルフプレジャーを安心して楽しむためには、
アイテムの除菌ケアも大切なこと。
体に触れるものだからお肌に優しい成分で、
いつも使うものだから手軽に扱えるものを。
そんな思いから、iroha専用クリーナーをつくりました。
ワンプッシュで出てくるふわふわの泡をアイテムに付けて、
ティッシュなどで拭き取るだけの簡単ケア。
銀イオンと、マイルド殺菌成分イソプロピルメチルフェノール配合で、
大切なアイテムを除菌します。
さらに、弱酸性でできているから、
プレジャータイムの前後を選ばずご使用いただけます。
無香料
内容量:50mL
生産国:日本
使用期限:3年(未開封)開封後はなるべくお早めにご使用ください。
全成分 : 水、BG、デシルグルコシド、ココイルグルタミン酸TEA、酸化銀、o-シメン-5-オール、クエン酸、クエン酸Na、フェノキシエタノール
アイテムの除菌ケアも大切なこと。
体に触れるものだからお肌に優しい成分で、
いつも使うものだから手軽に扱えるものを。
そんな思いから、iroha専用クリーナーをつくりました。
ワンプッシュで出てくるふわふわの泡をアイテムに付けて、
ティッシュなどで拭き取るだけの簡単ケア。
銀イオンと、マイルド殺菌成分イソプロピルメチルフェノール配合で、
大切なアイテムを除菌します。
さらに、弱酸性でできているから、
プレジャータイムの前後を選ばずご使用いただけます。
無香料
内容量:50mL
生産国:日本
使用期限:3年(未開封)開封後はなるべくお早めにご使用ください。
全成分 : 水、BG、デシルグルコシド、ココイルグルタミン酸TEA、酸化銀、o-シメン-5-オール、クエン酸、クエン酸Na、フェノキシエタノール
キャンペーン
Campaign
ランキング
新着情報
News
日頃よりのご愛顧、誠にありがとうございます。
昨今、クレジットカードの不正利用が多発しております。
クレジットカードご利用時に、ご本人様確認をさせていただく場合がございます。
お客様におかれましてはご不便をおかけいたしますが、ご了承頂きますよう宜しくお願い致します。
昨今、クレジットカードの不正利用が多発しております。
クレジットカードご利用時に、ご本人様確認をさせていただく場合がございます。
お客様におかれましてはご不便をおかけいたしますが、ご了承頂きますよう宜しくお願い致します。
2023年12月31日〜2024年1月3日の4日間、営業時間を10:00〜21:00に変更させていただきます。
秋葉原ラブメルシーを今後とも宜しくお願い致します。
秋葉原ラブメルシーを今後とも宜しくお願い致します。
2022年12月31日〜2023年1月3日の4日間、営業時間を11:00〜21:00に変更させていただきます。
秋葉原ラブメルシーを今後とも宜しくお願い致します。
秋葉原ラブメルシーを今後とも宜しくお願い致します。
「東京2020オリンピック・パラリンピック競技大会」に伴い、
競技開催中、選手村開村期間はお客様への配送に遅延が生じる場合がございます。
詳しくは各運送会社HPをご覧ください。
競技開催中、選手村開村期間はお客様への配送に遅延が生じる場合がございます。
詳しくは各運送会社HPをご覧ください。
2021/02/01
リニューアル記念キャンペーン開催中!(〜3月31日まで)
2018/09/01
サイトオープンいたしました!
ページトップへ